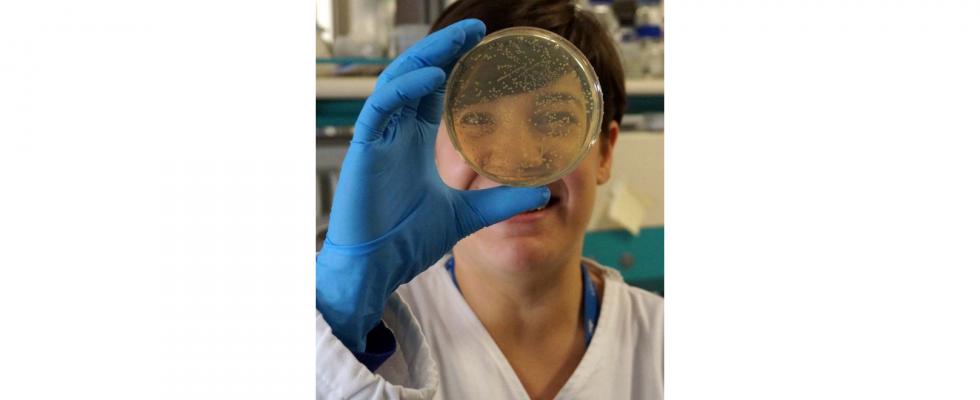

Antonello Mallamaci, Full Professor in Molecular Biology and Head of the Laboratory of Cerebral Cortex Development.
Vivi felice.
Live happy.
Domenico Scarlatti. Essercizi per gravicembalo, introduzione. Excercises for harpsichord, foreword. (1738)
Reason is, and ought only to be the slave of the passions, and can never pretend to any other office than to serve and obey them.
David Hume. A treatise on human nature, book II, part III, section III. (1739)
Aufklärung ist der Ausgang des Menschen aus seiner selbstverschuldeten Unmündigkeit. Unmündigkeit ist das Unvermögen, sich seines Verstandes ohne Leitung eines anderen zu bedienen. Selbstverschuldet ist diese Unmündigkeit, wenn die Ursache derselben nicht am Mangel des Verstandes, sondern der Entschließung und des Muthes liegt, sich seiner ohne Leitung eines anderen zu bedienen. Sapere aude! Habe Muth, dich deines eigenen Verstandes zu bedienen!
Enlightenment is the human being’s emergence from his self-incurred minority. Minority is inability to make use of one’s own understanding without direction from another. This minority is self-incurred when its cause lies not in lack of understanding but in lack of resolution and courage to use it without direction from another. Sapere aude! Have courage to make use of your own understanding!
Immanuel Kant. Beantwortung der Frage: Was ist Aufklärung? An Answer to the Question: What is Enlightenment? (1784)
Dobbiamo inventare il mondo per inquadrarvi le nostre sensazioni, ma non dovremo mai considerarlo come uno schema rigido e fisso, come una costruzione definititiva: esso non e' che il risultato provvisorio di uno sforzo di sintesi.
We have to invent the world and frame our sensations within it, but we must not consider it as a rigid and fixed scheme, as an ultimate building: it is not but the provisional result of our synthesis efforts.
Bruno de Finetti. L'invenzione della verità. The invention of truth. (1934)